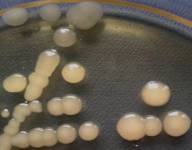
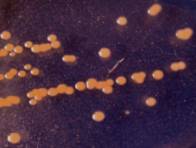
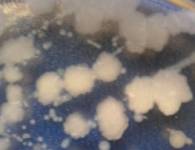

Рой И. Ю., д.х.н. Клименко Н. А., д.б.н.
Здоровенко Г. М.
Институт коллоидной химии и химии воды
имени А. В. Думанского, Украина
ХАРАКТЕРИСТИКА УСТОЙЧИВОСТИ К СОЕДИНЕНИЯМ ХЛОРА МИКРООРГАНИЗМОВ ВОДЫ ПО
КУЛЬТУРАЛЬНО-МОРФОЛОГИЧЕСКИМ ПРИЗНАКАМ
Введение. Доочистка водопроводной воды для нужд
производства на предприятиях пищевой промышленности является распространенной
практикой для удаления из воды остаточных концентраций природных органических
веществ, микроорганизмов и кондиционирования качества воды. Чаще всего для этих
целей используют систему очистительных устройств, включающих кварцевые и
угольные фильтры, ионообменную корректировку минерального состава воды и
дегазацию. Для предотвращения микробного загрязнения воды в процессе такой
доочистки фильтры подвергают периодической тепловой обработке и дезинфекции
хлорсодержащими реагентами. Известно, что в питьевой водопроводной воде,
которая поступает из системы водораспределения в систему доочистки может
присутствовать большое разнообразие микробных филотипов: от 173 до 333. В
таксономическом составе микробных сообществ доминируют представители Proteobacteria
(57,2 – 77,4 %) широко распространенных классов Alphaproteobacteria, Betaproteobacteria,
Gammaproteobacteria и Deltaproteobacteria. Однако, было установлено, что большая часть
последовательностей рибосомных меток ДНК (6,3 – 36,5 %) отдаленно относятся к
базе данных последовательностей неизвестной филогенетической принадлежности [1]. Выявляются также другие бактериальные
группы представленные видами Cyanobacteria, Actinobacteria,
Bacteroides и Planctomycetes. Эти бактериальные
филотипы находятся среди потенциально активных в питьевой воде. Предполагается,
что они могут играть важную роль в биохимических процессах в питьевой воде [2].
Несмотря на
то, что в настоящее время индикаторный показатель микробиологического
мониторинга качества питьевой воды (колииндекс и колититр), являются главным
инструментом оценки микробиологической безопасности воды после обеззараживания
соединениями хлора, в последнее время исследователи полагают, что такой подход
может быть недостаточным для оценки микробиологической безопасности питьевой
воды [3, 4]. Согласно литературным данным [5, 6, 7] микроорганизмы, в том числе кишечная палочка, под воздействием
неблагоприятных факторов и особенно соединений хлора, как основных средств
обеззараживания воды, испытывают сублетальное воздействие. Это обуславливает
наличие жизнеспособных, но некультурабельных бактерий в системах
водораспределения после обеззараживания хлором и возникновение эффекта
резистентности бактерий к хлору и его соединениям.
Не так давно была сформулирована гипотеза хлоррезистентности бактерий с фундаментальных позиций супрамолекулярной
химии [8, 9], согласно которой в основе резистентности к биоцидам в целом и хлоррезистентности
в частности лежит сложный процесс информационно – пространственного
взаимодействия рецептора и субстрата. Заключительным звеном формирования
резистентности бактерий к хлору, как биоцида, является биопленка, где
происходит обмен генами резистентности между бактериями. Воду, при этом, можна
рассматривать, как идеальную среду для
горизонтально передачи генов, в которой микроорганизм передает
генетический материал даже неродственной клетке. Такая передача генов – обычное
явление взаимодействия между бактериями отдаленных таксонов. Гены
повышенной устойчивости к хлору могут также передаваться биопленками систем
водоснабжения [10].
По мнению [11]
проблема адаптивной мультирезистентности бактерий к хлору, как дезинфектанта, тесно связана с гормезисом - двухфазовое
действие химических веществ (ксенобиотиков, лекарств и природных ядов), при
котором малые дозы вызывают стимуляцию, а большие - ингибирование биологических показателей. Показано, что
горметические зависимости «доза - эфект» встречаются у представителей биоты
всех уровней организации, начиная от вирусов и бактерий и заканчивая приматами
и человеком с широким диапазоном доз [12].
Исследователи [11]
выдвинули гипотезу о связи резистентности и гормезиса, в которой говорится о
том, что хлор и его соединения, как основные средства обеззараживания воды во
всем мире, делают определеный вклад в стойкость водной микробиоты. Так как хлор
в остаточных концентрациях, среди других факторов, проявляет горметическое
стимулирующее действие на рост бактерий, это гипотетически является фактором
влияющим на стабильность их циркуляции в водной среде и питьевой воде.
Кроме
эффекта резистентности бактерий к соединениям хлора в питьевой воде вследствие активного
синтеза экзополисахарида (ЭПС) микроорганизмами биопленки, наявности curli-пилей
[13], и
явления гормезиса могут присутствовать группы микроорганизмов – факультативные
анаэробы, способные восстанавливать кислородные соединения хлора, как
терминальные акцепторы электронов. Наличие таких микроорганизмов в системе водоподготовки
пищевого предприятия и других производств было показано в работах [14, 15].
Цель работы: выделить индивидуальные культуры
бактерий из преобладающих микроорганизмов выделенных из проб питьевой водопроводной
воды и проб воды отобранной на различных
этапах очистки на установке водоподготовки предприятия специальных напитков; изучить
культурально-морфологические свойства выделенных микроорганизмов и их устойчивость по отношению к хлору (NaOCl),
как основного средства обеззараживания воды.
Основной
материал. В
работе исследовали пробы питьевой водопроводной воды, а также пробы этой же
воды отобранные на различных этапах очистки установки водоподготовки
предприятия специальных напитков. Вода, что прошла все стадии доочистки и
подготовки, является исходным сырьем при производстве специальных напитков. В
систему водоподготовки вода поступала
из городского водопровода и соответствовала нормативным требованиям к питьевой
воде (ДСанПиН 2.2.4-400-10 [16]). Питьевую водопроводную воду с целью доочистки пропускают через систему
очистительных устройств состоящих из резервуаров-накопителей водопроводной
воды, песчаных фильтров, угольных фильтров, дегазатора, буферных резервуаров
очищенной воды. Для предупреждения развития нежелательной микрофлоры в
технологии водоподготовки предусмотрено обеззараживание воды и дезинфекция
оборудования, которые проводят в резервуарах-накопителях (точка 1), перед
песчаными фильтрами (точка 2) и в буферных резервуарах (точка 3).
Обеззараживание осуществляли
гипохлоритом натрия. Дозы хлора составляли: в точке 1 – в количестве
необходимом для обеспечения концентрации свободного хлора на уровне 0,4 – 0,5
мг/дм³; в точке 2 – доведение содержания свободного хлора до 0,9 мг/дм³;
в точке 3 – обеспечение остаточной концентрации свободного хлора 0,04
мг/дм³. Дезинфекцию оборудования проводят 2 % раствором гипохлорита
натрия.
Исследуемые
образцы воды были стерильно отобраны со следующих этапов очистки: питьевая вода
из городского водопровода; вода из
накопительных резервуаров; после песчаного фильтра; после угольного фильтра;
после Н-катионных фильтров; после дегазатора; очищенная вода из буферных резервуаров. Бактерии выделяли
методом мембранной фильтрации. Для этого по 100 мл исследуемой воды фильтровали
через стерильные фильтры для микробиологических целей EZ PAK
036 с
диаметром пор 0,45 мкм и диаметром диска 47 мм. Фильтры помещали на чашки Петри
с мясопептонным агаром (МПА), инкубировали при температуре (28 ± 1) °С в
течение (48 ± 2) ч.
Нами были изолированы колонии доминирующих
микроорганизмов, которые выросли на фильтрах и прошли все стадии очистки установки
водоподготовки в условиях периодической дезинфекции фильтров гипохлоритом
натрия и тепловой обработки. Изучаемые культуры были обозначены V, Y, O, W
(рис. 1).
|
V |
Y |
O |
|
W |
Рис
1. Морфолого-культуральные особенности роста бактериальных изолятов на
плотной питательной среде.
|
|
Как видно из
рис. 1, три бактериальные культуры V, Y, O, относятся
к колониям S-типа, а именно круглые, гладкие и выпуклые, с ровными
краями и блестящей поверхностью. Изолят V- бесцветный, Y и O
пигментированы в желтый и оранжевый цвет соответственно. В то время, как
культура W так же бесцветна, но отличается неправильной
формой, слегка шероховатой поверхностью и более крупными размерами КОЕ - R-
диссоциация.
При изучении
характера роста бактерий на жидкой питательной среде обнаружено, что только
культура W образует плотную
морщинистую пленку в интерфазе жидкость/воздух (пелликулу), что согласно [17, 18] может свидетельствовать о способности бактерии формировать фиксированую
на поверхности биопленку. Культура О отличается от других изолятов способностью
проявлять чисто дифузный рост (планктонная форма роста без признаков асоциаций
микробных клеток). Изоляты V и Y
образовывали осаждающиеся на дне пробирки флоккулы (рис. 2).
|
V |
Y |
O |
W |
Окраска по
Граму показала следующие результаты (рис. 3).
|
V |
Y |
|
O |
W |
Рис.
3 Окраска по Граму выделенных типов микроорганизмов.
Все исследованные культуры относятся к грамположительным бактериям, форма клеток
- палочковидная у образцов V, O, W. Только
изолят Y - представлен коками.
Определяли
устойчивость выделенных нами чистых
культур бактерий по отношению к хлору. Показатель устойчивости микроорганизмов
к хлору, которые колонизируют системы очистки воды и доочистки питьевой воды,
является важным для оценки качества получаемой воды. Для проведения анализа
использовали суточные культуры бактерий. Микробную массу смывали 50 мл
стерильной питьевой водопроводной воды, используемой на производстве для
доочистки. Смывы встряхивали на аппарате Шуттеля в течение 30-40 мин.
Полученную однородную микробную суспензию стандартизировали по стандарту
мутности до 5 единиц (0,5 млрд/1 мл). Далее готовили серию разведений и
доводили плотность исследуемой суспензии микробных клеток до 5×104/см3
(оптимальная плотность суспензии микробных клеток для визуального подсчета
колоний образующих единиц, КОЕ). В качестве контроля 0,1 мл каждой разведенной микробной суспензии сеяли
на чашки Петри с МПА (поверхностный метод),
инкубировали при температуре (28 ± 1) °С в течение (48 ± 2) ч. Для
определения устойчивости к хлору к 1 мл
каждой разведенной микробной суспензии добавляли раствор NaOCl
в следующих концентрациях: 1,4; 3; 5; 7 мг/л. Инкубировали 5, 10, 20 и 60 мин
при 28 ± 1 °С. Далее отбирали по 0,1
мл каждой испытуемой микробной суспензии и поверхностным методом высевали на
чашки Петри с МПА, инкубировали при
температуре (28 ± 1) °С в течение (48 ±
2) ч. Через 2 суток подсчитывали КОЕ, сравнивая
количество выживших бактериальных клеток с контролем, а также рассчитывали
количество чувствительных и нечувствительных микроорганизмов по отношению к
хлор (табл. 1).